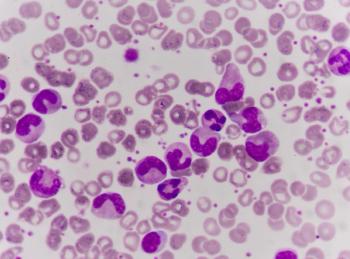

Immunoglobulins
Latest News
Latest Videos

Shorts

CME Content
More News

IVIG-Glucocorticoid Combination Therapy Reduces Need for Adjunctive Immunotherapy in Pediatric MIS-C
Glucocorticoids alone were found to reduce treatment failure and fever duration, but the combination with intravenous immunoglobulin (IVIG) significantly reduced the need for adjunctive immunotherapy following treatment.

Subcutaneous immunoglobulin was found to elicit fewer viral infections compared with other routes of immunoglobulin replacement therapy, including intravenous immunoglobulin.

Juan Ovalles, MD, PhD, discusses how high placebo response rates driven by background therapy complicate lupus drug trials, and outlines evolving strategies in trial design, clinical practice, and pharmacist-led care to ensure investigational biologics are fairly evaluated and appropriately used in systemic lupus erythematosus.

Subcutaneous immunoglobulin (SCIg) is a hopeful alternative to intravenous immunoglobulin in patients with inflammatory myositis due to a lack of adverse effects and fewer financial constraints.

IVIG treatment significantly boosts platelet counts in pregnant people with thrombocytopenia, revealing key predictors for effective response and optimizing clinical decisions.

Additional intravenous immunoglobulin (IVIG) treatment shows promise for patients with Kawasaki disease who are resistant to infliximab, potentially matching the efficacy of second IVIG doses in patients resistant to IVIG.

Despite being an effective treatment option, intravenous immunoglobulin (IVIG) can cause transient adverse events in pediatrics with primary immunodeficiency, including headache and fever.

Intravenous immunoglobulin (IVIG) treatment for dermatologic conditions shows effectiveness but poses risks of kidney decline and thromboembolism, necessitating careful monitoring.

New trial results highlight intravenous immunoglobulin (IVIG) 10% as an effective rescue treatment for relapsing chronic inflammatory demyelinating polyradiculoneuropathy (CIDP), enhancing patient care and pharmacist involvement in management.

A study reveals IVIG treatment shows no significant benefits over tocilizumab for severe COVID-19, highlighting higher adverse events and costs.

Although the rate of coronary artery lesions decreased across both cohorts of this trial of children with Kawasaki disease, there were no differences in lesion reduction between those receiving intravenous immunoglobulin (IVIG) alone and those receiving IVIG with aspirin.

Pharmacists should educate patients about their treatment regimen and potential adverse effects.

Given rituximab’s tendency to cause infections in patients being treated for autoimmune diseases, the addition of intravenous immunoglobulin works to reduce that risk and induce clinical improvements.

Evidence-based guidelines support the safe and effective administration of Ig therapy in clinical practice.

As indicated by prior literature, a second dose of intravenous immunoglobulin (IVIG) in patients with Guillain-Barré syndrome increases serum immunoglobulin G levels without improving clinical outcomes.

Though rare and typically presenting as transient, a case study demonstrates severe, chronic neutropenia in a patient with multifocal motor neuropathy treated with intravenous immunoglobulin (IVIG).

Given the increasing age of patients with generalized myasthenia gravis, knowing which therapies are most effective for different subgroups is essential.

Plasma therapy can involve burdensome procedures and infusions for patients, but pharmacists can use their expertise to make the process easier and more convenient.

Compared with other treatments for myasthenia gravis, nipocalimab demonstrated more significant improvements in disability scores, with tolerable safety.

Often an indicator of fibrosis or damage to the heart, late gadolinium enhancement was found to be unaffected by the administration of intravenous immunoglobulin (IVIG) in pediatric patients with myocarditis.

These results provide a pediatric lens into the potential risk of thromboembolic events in patients with dermatomyositis.

An infusion and specialty clinical pharmacist is a valuable integrated member of the health care team as demonstrated by cost avoidance and high satisfaction reported by both veterans and specialty providers.

A series of patient cases demonstrates the potential harm that patients with chronic inflammatory demyelinating polyneuropathy (CIDP) may face when transitioning from intravenous immunoglobulin (IVIG) to FcRn therapy.
Admissions to the hospital for fever were reduced in pediatric patients with medium-risk ALL receiving intravenous immunoglobulin, a potentially useful finding to help prevent infections in vulnerable patients.

Managing comorbidities, ensuring proper dosing, and treating IVIG-related adverse events are areas where pharmacists play a large role.